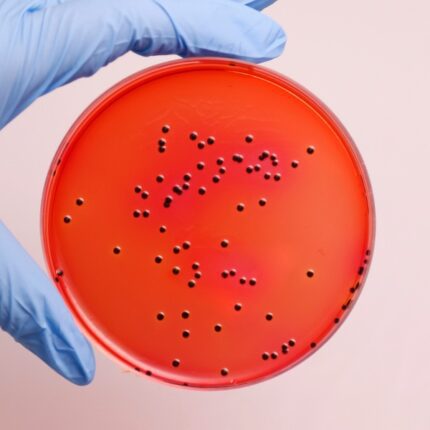
محیط کشت XLD , 105287 , فروش محیط کشت XLD, خرید محیط کشت XLD

محیط کشت VRBD
فروش محیط کشت VRBD به انگلیسی : VRBD (Violet Red Bile Dextrose) agar با کد 110275 برند مرک اصل با کیفیتی تضمینی در آرمان کیمیا زیست، تامین کننده مواد شیمیایی آزمایشگاهی با بیش از ۳۰ سال سابقه، جهت خرید محیط کشت VRBD با ما تماس بگیرید یا شماره تماس خود را وارد نمائید تا کارشناسان فروش در اسرع وقت با شما تماس بگیرند
جدول خصوصیات محلول
| pH |
7.3 (40 g/l, H₂O, 37 °C) (after autoclaving) |
|---|---|
| حجم | , |
| دیگر نامها |
,
VRBD-agar (Crystal-violet neutral-red bile dextrose agar) acc. to MOSSEL |
| کد محصول | , |
| کشور سازنده |
آلمان |
| کمپانی سازنده |
سیگما الدریچ (Sigma-Aldrich) ,مرک (Merck) |
محیط کشت VRBD چیست؟
محیط کشت VRBD یا به فارسی «آگار ویولت رد بایل دکستروز» یکی از محیطهای کشت تخصصی و کارآمد در میکروبیولوژی است که به منظور تشخیص و شمارش باکتریهای گرم منفی بویژه انتروباکتریاسهها در نمونههای غذایی و دیگر نمونهها استفاده میشود.
این محیط کشت توسط شرکت مرک با کد ۱۱۰۲۷۵ عرضه میگردد.
خواص فیزیکوشیمیایی
آگار ویولت رد بایل دکستروز دارای ویژگیهای فیزیکوشیمیایی منحصر به فردی است که آن را برای استفاده در آزمایشگاههای میکروبیولوژی ایدهآل میسازد. این محیط کشت شامل ترکیباتی است که به عنوان مواد انتخابی و تشخیصی عمل میکنند:
- pH: در حدود ۷.۴ ± ۰.۲
- رنگ: بنفش قرمز
- مواد تشکیلدهنده اصلی: پپتون، عصاره مخمر، دکستروز، و نمکهای صفراوی که به عنوان عوامل انتخابی عمل میکنند.
کاربردها
این محیط کشت به ویژه برای تشخیص و شمارش باکتریهای انتروباکتریاسه که در محیطهای مختلف نظیر مواد غذایی، آب و نمونههای بالینی حضور دارند، استفاده میشود. حضور دکستروز در ترکیب این محیط کشت، امکان شناسایی و تشخیص بهتر باکتریهای تخمیرکننده دکستروز را فراهم میآورد.
مزایا
- حساسیت بالا: امکان تشخیص و شمارش دقیق باکتریهای هدف
- سهولت در استفاده: آمادهسازی ساده و سریع
- کاربرد گسترده: مناسب برای انواع نمونههای غذایی و محیطی
حجمها و بستهبندی
در بستهبندیهای مختلف و با حجمهای متنوع عرضه میشود که بسته به نیاز آزمایشگاهها میتوان آن را انتخاب نمود. بستهبندیهای رایج شامل ظروف ۵۰۰ گرمی و ۵ کیلوگرمی است.
نتیجهگیری
محیط کشت آگار ویولت رد بایل دکستروز یک ابزار اساسی و کارآمد برای تشخیص و شمارش باکتریهای گرم منفی در آزمایشگاههای میکروبیولوژی است. با داشتن خواص فیزیکوشیمیایی مطلوب و کاربردهای گسترده، این محیط کشت یک گزینه عالی برای استفاده در تحقیقات و آنالیزهای میکروبیولوژی است. برای تهیه و اطلاعات بیشتر، میتوانید به سایت شرکت مرک مراجعه کنید.

آرش –
کیفیت محصول سیگما آلدریچ هم بینقص بود